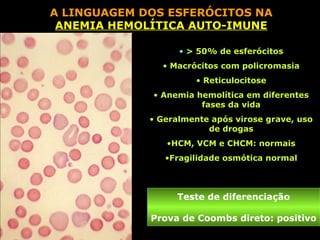
A LINGUAGEM DOS ESFERÓCITOS NA
 ANEMIA HEMOLÍTICA AUTO-IMUNE

                   • > 50% de esferócitos
               • Macrócitos com policromasia
                      • Reticulocitose
             • Anemia hemolítica em diferentes
                       fases da vida
             • Geralmente após virose grave, uso
                         de drogas
                •HCM, VCM e CHCM: normais
                •Fragilidade osmótica normal



                  Teste de diferenciação

             Prova de Coombs direto: positivo
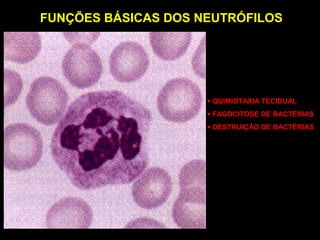
FUNÇÕES BÁSICAS DOS NEUTRÓFILOS




                     • QUIMIOTAXIA TECIDUAL
                     • FAGOCITOSE DE BACTÉRIAS
                     • DESTRUIÇÃO DE BACTÉRIAS
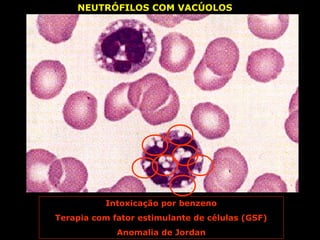
NEUTRÓFILOS COM VACÚOLOS




          Intoxicação por benzeno
Terapia com fator estimulante de células (GSF)
             Anomalia de Jordan
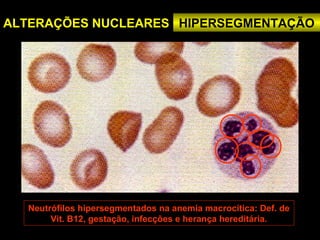
ALTERAÇÕES NUCLEARES HIPERSEGMENTAÇÃO




  Neutrófilos hipersegmentados na anemia macrocítica: Def. de
       Vit. B12, gestação, infecções e herança hereditária.
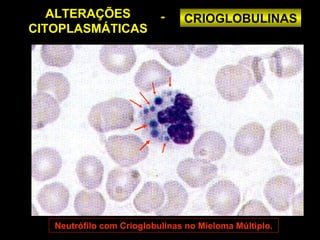
ALTERAÇÕES              -    CRIOGLOBULINAS
CITOPLASMÁTICAS




   Neutrófilo com Crioglobulinas no Mieloma Múltiplo.
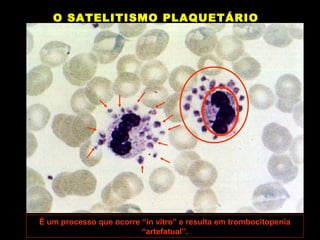
O SATELITISMO PLAQUETÁRIO




É um processo que ocorre “in vitro” e resulta em trombocitopenia
                         “artefatual”.
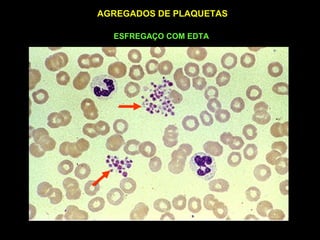
AGREGADOS DE PLAQUETAS

  ESFREGAÇO COM EDTA

O documento discute a linguagem das células do sangue humano, descrevendo alterações morfológicas e funcionais dos eritrócitos e leucócitos em diferentes condições patológicas. É apresentada uma descrição detalhada das causas e características citológicas da esferocitose, piropoiquilocitose e anemias hemolíticas, com foco nos achados morfológicos dos eritrócitos. Também são descritas as principais funções e alterações dos neutrófilos.